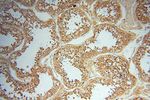
AKAP14 Antibody in Immunohistochemistry (Paraffin) (IHC (P))

Search
Proteintech
AKAP14 Polyclonal Antibody
{{$productOrderCtrl.translations['antibody.pdp.commerceCard.promotion.promotions']}}
{{$productOrderCtrl.translations['antibody.pdp.commerceCard.promotion.viewpromo']}}
{{$productOrderCtrl.translations['antibody.pdp.commerceCard.promotion.promocode']}}: {{promo.promoCode}} {{promo.promoTitle}} {{promo.promoDescription}}. {{$productOrderCtrl.translations['antibody.pdp.commerceCard.promotion.learnmore']}}
产品信息
14622-1-AP
种属反应
宿主/亚型
分类
类型
抗原
偶联物
形式
浓度
规格
纯化类型
保存液
内含物
保存条件
运输条件
产品详细信息
Immunogen sequence: MSETQNSTS QKAMDEDNKA ASQTMPNTQD KNYEDELTQV ALALVEDVIN YAVKIVEEER NPLKNIKWMT HGEFTVEKGL KQIDEYFSKC VSKKCWAHGV EFVERKDLIH SFLYIYYVHW SISTADLPVA RISAGTYFTM KVSKTKPPDA PIVVSYVGDH QALVHRPGMV RFRENWQKNL TDAKYSFMES FPFLFNRV (1-197 aa encoded by BC066357)
靶标信息
The A-kinase anchor proteins (AKAPs) are a group of structurally diverse proteins, which have the common function of binding to the regulatory subunit of protein kinase A (PKA) and confining the holoenzyme to discrete locations within the cell. This gene encodes a member of the AKAP family. The protein anchors PKA in ciliary axonemes and, in this way, may play a role in regulating ciliary beat frequency. Alternate transcriptional splice variants, encoding different isoforms, have been characterized.
仅用于科研。不用于诊断过程。未经明确授权不得转售。
篇参考文献 (0)
生物信息学
蛋白别名: A kinase (PRKA) anchor protein 14; A-kinase anchor protein 14; A-kinase anchor protein 28 kDa; A-kinase anchoring protein 28; AKAP 28; AKAP-14; AKAP28; AKAP28B; AKAP28C; PRKA14; Protein kinase A-anchoring protein 14
基因别名: AKAP14; AKAP28; PRKA14
UniProt ID: (Human) Q86UN6
Entrez Gene ID: (Human) 158798